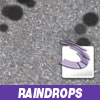

C4D RELEASE 10
PART TWO: Shortcuts get easier
Focus on Blur
 In a few steps, a very straightfoward graphic created in Adobe Photoshop or Illustrator can be transformed into a fluid moving background for use in motion graphic designs. When the client provides specific artwork, and requests it to be used, here's one way of blurring the boundaries of the "use" definition.
Read More In a few steps, a very straightfoward graphic created in Adobe Photoshop or Illustrator can be transformed into a fluid moving background for use in motion graphic designs. When the client provides specific artwork, and requests it to be used, here's one way of blurring the boundaries of the "use" definition.
Read More
RAINDROPS IN AE
Ame, ame, fure, fure..." Rain, rain, fall, fall. It's the season for rain in Los Angeles. While we do have falling leaves here, and other seasonal icons, most Angelenos think of "rain" as a winter season icon. In this tutorial, Steve Toyama takes you through a procedure to make wet pavement.
Read More Ame, ame, fure, fure..." Rain, rain, fall, fall. It's the season for rain in Los Angeles. While we do have falling leaves here, and other seasonal icons, most Angelenos think of "rain" as a winter season icon. In this tutorial, Steve Toyama takes you through a procedure to make wet pavement.
Read More
Knoll LF Training
 Now that Knoll Light Factory is available for every popular professional application, including Adobe After Effects, Premiere Pro, Photoshop, Eyeon's Digital Fusion, Autodesk Combustion, Smoke, Flame, Apple Final Cut Pro, Motion, and Avid, editors and compositors need to know how to use it effectively.
Read More Now that Knoll Light Factory is available for every popular professional application, including Adobe After Effects, Premiere Pro, Photoshop, Eyeon's Digital Fusion, Autodesk Combustion, Smoke, Flame, Apple Final Cut Pro, Motion, and Avid, editors and compositors need to know how to use it effectively.
Read More
3D Ghosts Sheets
 In the world of broadcast promo, it's been a mad push for fall campaigns all summer long, and chances are that you've already finished your Halloween campaigns by now (and they're airing), but if you haven't, here's an easy way to create some 3D 'bedsheet' ghosts with CINEMA 4D's MOCCA module.
Read More In the world of broadcast promo, it's been a mad push for fall campaigns all summer long, and chances are that you've already finished your Halloween campaigns by now (and they're airing), but if you haven't, here's an easy way to create some 3D 'bedsheet' ghosts with CINEMA 4D's MOCCA module.
Read More
Animating Materials
 There are several parameters that most C4D users are comfortable animating. Obviously position, scale and rotation, the basic transformation attributes are easily modified and animated, but what happens when you want to animate a texture. You have multiple options.
Read More There are several parameters that most C4D users are comfortable animating. Obviously position, scale and rotation, the basic transformation attributes are easily modified and animated, but what happens when you want to animate a texture. You have multiple options.
Read More - Front
page articles - Front
page articles |
10/17/06
Russian site goes on media offensive to deny violating copyright laws with sale of cheap music
10/17/06
Visioneer Intros Entry-Level Scanner
10/17/06
TechSmith Debuts Screencast.com Video and Multimedia Service for Business and Academic Professionals
10/17/06
New RFID Solutions from Loftware to Debut at the 2006 EPC Global U.S. Conference in Los Angeles
10/17/06
Nokia's New Carbide.ui Tool Lets Graphics and Creative Pros Customize S60 Smartphone User Interfaces
10/16/06
IFC Launches Website
10/16/06
MTV Networks Nabs Quizilla
10/16/06
Bravo Finds Web
10/16/06
IP Unity Hires 2 VPs
| ||||||||||||||||||||||||||||||||
Digital favorites
- Casino Online Non Aams
- Betting Sites UK
- Casino UK Sites
- Casino Online Non Aams
- Casino Non Aams
- Casinos Not On Gamstop
- UK Online Casinos Not On Gamstop
- Meilleur Casino En Ligne
- Crypto Casinos
- Casino Online Italia
- Migliori Giochi Casino Online
- Meilleur Casino En Ligne Français
- Casino En Ligne
- Meilleur Casino En Ligne Francais
- Siti Scommesse Non Aams
- Siti Poker Online Migliori
- Meilleur Site De Poker
- Site De Paris Sportif Nouveau
- Sweet Bonanza Fruits Avis
- Parier Sur Ufc
- Fm카지노 가입코드
- 비트코인 스포츠베팅
- Casino Jeux En Ligne
- Sites De Paris Sportifs
- Casino En Ligne Argent Réel
- Cresus Casino Avis
- Migliore Casino Non Aams
- Meilleur Casino En Ligne
- Meilleur Casino En Ligne 2026
- Casino En Ligne Fiable
- Casino En Ligne
- Migliori Casino Crypto
- Bonus Free Spin Senza Deposito
- Casino Online Non Aams Sicuri
- Migliori Siti Scommesse Non Aams
- Meilleur Casino En Ligne De France
- Casino En Ligne
- Casino En Ligne Fiable
- Trusted Online Casino Malaysia
- Nouveau Casino En Ligne 2026
- オンラインポーカー
- Casino En Ligne Cashlib
| canon digital camera |
 |
Canon Rebel XT 8.0MP Digital Camera
     (Rated by 49 users) (Rated by 49 users)
For convenience, ease of use and no compromise SLR performance, look no further than the EOS Digital Rebel XT. Price Range $519 to $1,049 • View Details • Related Items |

JR.com: $699.99 BlueStripe: $699.00 DellBusiness: $799.95 |
 |
Canon PowerShot SD600 Digital Camera
     (Rated by 38 users) (Rated by 38 users)
Sleek powerful and sophisticated the Power Shot SD600 Digital Camera from Canon packs easy-to-use features in an ultra-slim design. Price Range $208 to $350 • View Details • Related Items |

JR.com: $249.88 Crutchfield: $279.99 DellBusiness: $239.96 |
 |
Canon Powershot S3 IS Digital Camera
     (Rated by 25 users) (Rated by 25 users)
The sleek PowerShot S3 IS digital camera offers you high resolution, an extra-long zoom, advanced yet easy-to-use movie functions plus great new shooting options. Price Range $315 to $499 • View Details • Related Items |

TechForLess: $413.00 Crutchfield: $379.99 6ave.com: $351.00 |
 |
Canon PowerShot SD700 IS Digital Camera
     (Rated by 24 users) (Rated by 24 users)
6-megapixel recording (resolution up to 2816 x 2112), 2-1/2" LCD, optical image stabilizer, 4X optical zoom, 16:9 widescreen photo mode, high-speed USB, rechargeable battery ... Price Range $281 to $400 • View Details • Related Items |

TechForLess: $351.00 Crutchfield: $399.99 Toshiba: $399.99 |
 |
Canon PowerShot A620 Silver Digital Camera 7.1MP Digital Camera
     (Rated by 52 users) (Rated by 52 users)
You have never seen anything quite like the PowerShot A620. Price Range $209 to $333 • View Details • Related Items |

TechForLess: $320.00 New Connection: $209.00 Wild Digital: $333.00 |
 |
Canon PowerShot SD900 Digital Camera
     (Rated by 3 users) (Rated by 3 users)
Shoot sharp and impressive images with the PowerShot SD900 Digital Camera from Canon. Price Range $439 to $599 • View Details • Related Items |

JR.com: $499.99 PCNation: $484.70 DellBusiness: $499.00 |
HOT THREADS on DMN Forums
Page Title can't change using Dreamweaver Template Pages?!?
(1) • by blueStupa on the on the Web Design
forum
Mac vs PC color difference???
(1) • by Mark Griesbauer on the on the Adobe Photoshop
forum
**Professionally Trained Composer**
• by Mike Watts on the on the Demo Reels
forum
[FORUM NEWS] ONE DAY SALES (OCTOBER 23-27) LIMITED
• by Ko on the on the Plugin Central
forum
Adobe Photoshop Style Layer Tutorial
• by videxpertise on the on the Adobe Photoshop
forum
Object lable badly formatted
• by awilks on the on the Adobe Illustrator
forum
Thoughts on the Adobe Version of Dreamweaver?
• by blueStupa on the on the Macromedia Dreamweaver
forum
|
| Marketplace |
Laptop LCD Screen Replacement laptop screens for your high resolution graphics needs! We carry high resolution LCD screens for all brands including, Apple, Compaq, Dell, IBM, HP, Sony, Gateway,...Free CorelDraw Graphics Suite X3 Get the CorelDraw Graphics Suite X3 for free when you complete sponsor's survey!Free DigiMemo Digital Notepad Digitally capture and store handwritten notes for free! survey requiredGet your Designs noticed Stand out from the crowd. Place your design onto a professional looking CD or DVD. Primera offers CD-DVD Printers and disc duplicators to help you get your design out there.Laptop Screen We stock laptop LCD screens for all brands of notebooks including Dell, IBM, Compaq, Sony, Toshiba, Gateway, HP and more. We have thousands of laptop screens to fulfill your L...CD Ripping Service, iPod Loading Service We take cd collections and turn them into digital music for MP3 players and music servers. Quick turn around and professional service. Price includes shipping and insurance. ... |







